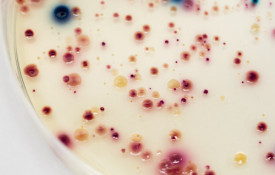

The Department of Environmental and Biological Sciences aims to promote healthy living in a healthy environment. Our research and education in the fields of environmental and biological sciences focuses on the interactions between humans and nature, with a multidisciplinary approach that is strongly based on natural sciences.
The department’s combination of interdisciplinary research fields is unique, and offers a good basis for our study programmes. Environmental health and technology and biology of environmental change are key themes for the future. Our biology teacher training introduces the latest research data to schools’ basic education.
Our multidisciplinary research is valued globally, and we are engaged in close cooperation with partners in Finland and abroad. An interdisciplinary research approach is applied to climate change and biodiversity loss – the health of the environment has various impacts on the well-being of humans as well.
The Department of Environmental and Biological Sciences has operations in both the Joensuu Campus and Kuopio Campus.
The Department of Environmental and Biological Sciences constitutes part of the Faculty of Science, Forestry and Technology.
150
Experts and professionals
550
Undergraduate and graduate students
100
Doctoral students
Studies
The Department of Environmental and Biological Sciences at the University of Eastern Finland (UEF) offers inspiring, research-based Master’s education for students who want to address global environmental and biological challenges. Our programmes are delivered in English at the vibrant Kuopio and Joensuu campuses and combine academic excellence with modern learning environments and flexible study pathways.
International students can apply directly to our English‑taught Master’s degree programmes. At the Kuopio Campus, you can choose between Environmental Health and Technology and Environmental and Ecosystem Ecology. At the Joensuu Campus, we offer Master’s programme in Biology of Environmental Change. All programmes are closely connected to active research communities, allowing students to learn from leading experts in their field.
UEF encourages you to design a degree that supports your personal interests and career goals. You can complement your major studies with a wide selection of English‑taught courses, including biochemistry, hydrobiology, chemistry, physics, geography, forestry, statistics, and environmental law. These interdisciplinary options strengthen your professional profile and enhance your employability in international and cross-sectoral careers.
Graduates from the Department of Environmental and Biological Sciences go on to work in research, expert, and specialist roles at universities, research institutes, government organisations, international agencies, educational institutions, and private companies in Finland and around the world.
International Master's degree programmes
Doctoral programme
Research
The focus areas of the research conducted at the Department of Environmental and Biological Sciences are aerosol research, aquatic research, and radiation and chemicals risks to humans and the environment. Another globally valued research area is the biology of environmental change.
At the Kuopio Campus, multidisciplinary research is conducted in environmental health and technology and the biology of environmental change. At the Joensuu Campus, research focuses on analysing the biological processes related to the changing ecological state of terrestrial and aquatic ecosystems.
The department participates in the university’s aquatic research, which brings together the university’s researchers specialising in aquatic research and research groups with an interdisciplinary approach. Aquatic research is aimed at building well-being and business that is based on more sustainable use of natural resources for eastern Finland. The expertise of our university and its partners is combined under a new research programme in the field of aquatic research.
Our research areas
Our research groups and projects
News and events
News
Social media
Contact information
University of Eastern Finland’s Student and Learning Services is responsible for providing general study-related administrative services for students and staff, as well as offer support for applicants.
Joensuu Campus
Postal address
University of Eastern Finland
Department of Environmental and Biological Sciences
P.O. Box 111
FI- 80101 JOENSUU
Street address
Yliopistokatu 7
Natura building
Email: firstname.surnaname(at)uef.fi
Kuopio Campus
Postal address
University of Eastern Finland
Department of Environmental and Biological Sciences
P.O. Box 1627
FI- 70211 KUOPIO
Street address
Yliopistonranta 8
Snellmania building
Email: firstname.surnaname(at)uef.fi